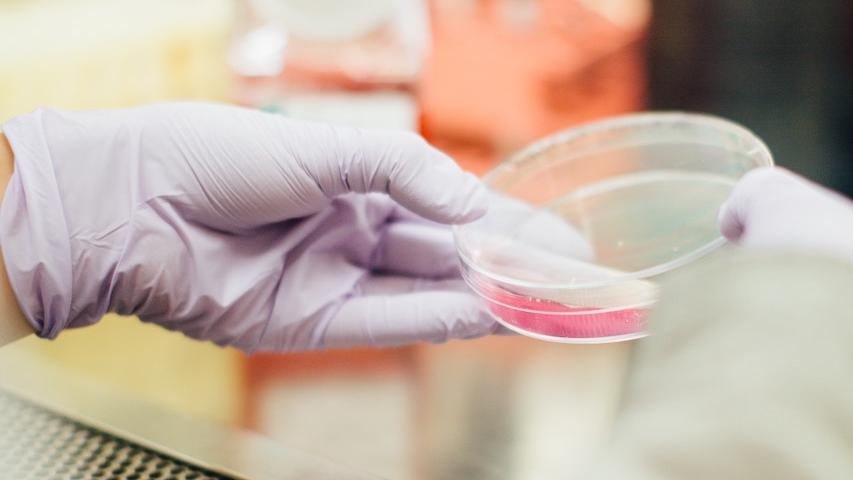

Científicos entrenan hormigas para detectar el cáncer en los seres humanos; estos insectos serían una opción más viable que los perros.
Y es que las hormigas, señaló el estudio realizado en Francia, son más precisas, económicas y menos invasivas que muchos otros estudios para la detección del cáncer.
Además de poder detectar el cáncer los científicos aseguraron que sus capacidades olfativas podrían utilizarse para la detección de armas y drogas.

Las hormigas son más viables que los perros para la detección del cáncer
De acuerdo con un articulo publicado en la revista “Science” las hormigas son más eficaces para detectar el cáncer en los humanos que los perros.
Y es que las hormigas, a diferencia de los perros, demostraron:
- Mejor sentido del olfato
- Necesitar menos tiempo de adiestramiento
- Ser más económicas
- Ser más prácticas
Para el estudio se utilizaron hormigas fórmicas, especie abundante en zonas templadas, las cuales demostraron ser capaces de detectar el cáncer y dos tipos de tumores mamarios.

¿Cómo se logró entrenar a las hormigas?
En Francia un grupo de científicos perteneciente al centro de Investigación Científica, CNRS, entrenó a un grupo de hormigas para detectar el cáncer en los seres humanos.
El entrenamiento a las hormigas consistió en un sistema simple de recompensas en el cual se colocaban dos placas Petri , una con células sanas y la otra con células cancerígenas.
A la placa con células cancerígenas se le colocó un poco de azúcar; después de “minutos” las hormigas lograron recordar la información y continuaron seleccionando las células cancerígenas incluso sin el azúcar.
Esto demostró que las hormigas lograron detectar el olor de la COV, compuestos orgánicos volátiles característicos de las células tumorales.
Debido a sus altas capacidades olfativas, los científicos señalaron que las hormigas también podrían tener otros empleos como la detección de armas y drogas; sin embargo, aún se necesita seguir investigando.